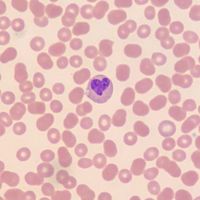

| Rank | Label Name | Creates number |
|---|---|---|
| 1 | UMG Recordings | 2 |
| 2 | Dave Robertson | 1 |
| 3 | Dreamville/Interscope Records | 1 |
| 4 | Mavin Global Holdings | 1 |
| 5 | P2022 | 1 |
| 6 | Planet Records Italy | 1 |
| 7 | 10K Projects/Capitol Records, ℗ 2023 Dolo Entertainment Inc., under exclusive license to 10K Projects and UMG Recordings | 1 |
| 8 | a Warner Records UK release, a division of WMUK Limited, ℗ 2021 PinkPantheress | 1 |
8 of 8 labels
| Rank | Label Name | Creates number |
|---|---|---|
| 1 | Universal Music Group | 6 |
| 2 | Warner Music Group | 3 |
2 of 2 labels